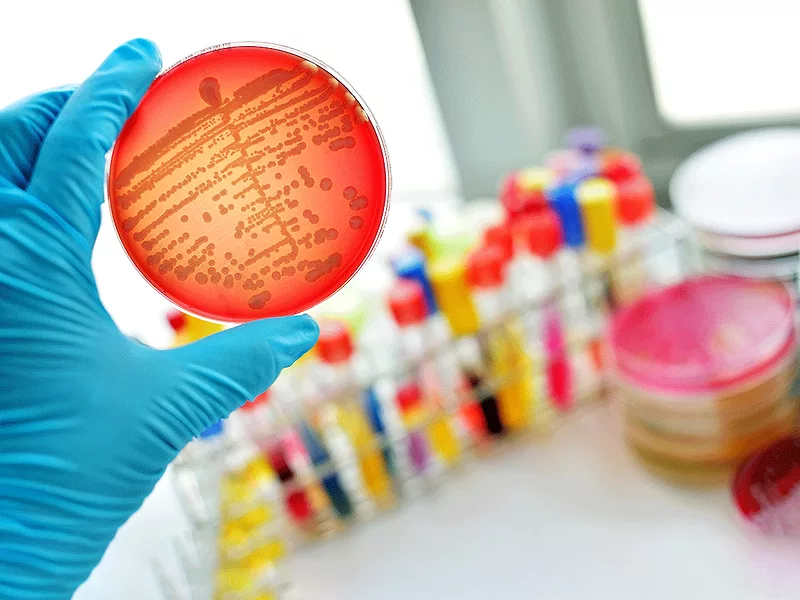
Gloved hand holding petri dish in lab Gloved hand holding petri dish in lab

A Chinese study led by scientists at Zhejiang University in Hangzhou City has identified a linker of resistance from the mobile colistin resistance gene 3 (MCR-3), which might represent a promising drug target against which to develop small-molecule inhibitors to reverse colistin resistance.
"We are first group to functionally define this linker as a facilitator of MCR-3 colistin resistance," said study co-leader Youjun Feng, a professor in Department of Pathogen Biology & Microbiology at Zhejiang University School of Medicine.
Antimicrobial resistance (AMR) represents an increasingly serious threat to global public health. Of particular concern is the rapid rise of resistance to colistin, or polymyxin E, the antibiotic of last resort against Gram-negative bacteria, including pneumonia.
"AMR is a major problem in many countries including China. New drug targets are lacking, which might be in part responsible for the poor availability of new antibiotics," said Feng, who co-led the study with Tingjun Hou, a professor in the College of Pharmaceutical Sciences at Zhejiang University.
Most colistin resistance is due to remodeling of lipopolysaccharide (LPS)-lipid A on the Enterobacterial surface.
However, unlike limited transferability of natural colistin resistance by clonal expansion, plasmids are know to facilitate global dissemination of MCR in Enterobacteriaceae.
Structural studies have proposed a trade-off for the action of MCR/EptA, a family of phosphoethanolamine (PEA)-lipid A transferases, which has been verified by functional assays of site-directed mutagenesis.
A widespread enzyme in LPS-containing Gram-negatives, lipid A-PEA transferase comprises a C-terminal catalytic domain connected with a transmembrane (TM) region at the N terminus.
Unlike most lipid A-PEA transferases, MCR is rare in that it has been shown to confer phenotypic polymyxin resistance.
Recently, 10 MCR variants (MCR-1 to MCR-10) have been recognized and ranked by phylogeny, suggesting an ongoing genetic activity occurs within the evolving MCR family with certain selection pressures.
The structure-to-function relationship shows that a conserved catalytic center, plus a similar phosphatidylethanol-amine (PE) substrate-loading tunnel, are shared among five MCR enzymes (MCR-1 to MCR-5) and four non-MCR enzymes.
Furthermore, these two functional motifs are required, but not sufficient for the enzymatic action of MCR-like enzymes and its resultant resistance.
Importantly, a structural element comprising a short linker of 59 residues long (Linker 59), between the TM region and the catalytic domain, occurs inside a given MCR member, which is evolved in protein domestication of lipid A-PEA transferases.
MCR Linker 59 is thought to determine enzymatic action and its resultant susceptibility to polymyxin in bacterial recipients, although this awaits further evidence.
Reported in the May 18, 2021, edition of Cell Reports, the new Chinese study was aimed at improving our understanding of the molecular mechanisms driving rapid MCR evolution.
The authors reported two unusual functional variants of MCR-3, designated Ah762 and Ah763, in Aeromonas hydrophila, which might arise from genetic duplication and amplification and Ah762 was shown to be active in colistin resistance.
"Among the two paralogs, Ah762 was shown to be active, whereas Ah763 not; functional cloning allowed us to determine that only Ah762 is active in rendering recipient Escherichia coli insusceptible to colistin," said Feng.
This is a significant finding, "as it implies that there is a unique molecular element that differentiates Ah762 from Ah763," he told BioWorld Science.
Interestingly, genetic mapping then identified a hinge linker 59 of Ah762. Further mapping showed that Linker 59 participates in the formation of the lipid A-binding cavity and determines MCR-3 colistin resistance.
More importantly, genetic characterization revealed that Linker 59 appears to act as a facilitator and could help other inactive MCR variants regain their function within the context of colistin resistance.
"There is a distinct possibility that this hinge-like linker 59 might constitute a promising drug target," Feng said.
"Domain-swapping analysis allowed us to observe that Linker 59 benefits the inactive MCR-3 variant regain function." Together with molecular dynamics simulation, isothermal titration calorimetry suggested this facilitator guarantees the formation of a substrate PE-accessible pocket within MCR-3-like enzymes.
In summary, these findings define a previously unknown MCR-3 facilitator governing colistin resistance, which provides a drug target candidate for developing small molecules to reverse MCR.
To this end, the Zhejiang University researchers are now screening and repurposing FDA-approved drugs against colistin resistance.
"The search for an appropriate new candidate drug is currently underway," noted Feng, "although at present it is not possible to predict how long this might take."